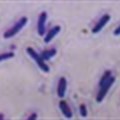
Metallic copper surfaces kill bacteria on contact

Subscribe to daily business and company news across 19 industries
×News



Infrastructure, Innovation & Technology
Earthshot Prize: 5 winners that will help solve major environmental problems

Promotions & Activations
Sorbet launches First Thursdays programme to kick off annual Beauty and Grooming Fairs


Environment & Natural Resources
Pareto Limited head office receives Green Star ratings



Environment & Natural Resources
Affluence is killing the planet, warn scientists


Infrastructure & Utilities
How technology could help rural South Africa turn sunshine into income






Facilities & Property Management
Lack of parliamentary oversight in Western Cape property deals